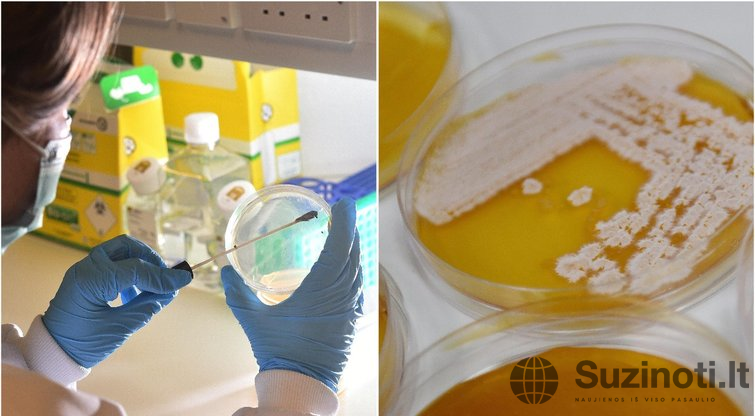

Mokslininkai skelbia rimtą įspėjimą – žmonijai gali grėsti egzistencinė katastrofa dėl mokslinių eksperimentų su vadinamaisiais veidrodiniais mikrobais. Pasak jų, tai nebe mokslinė fantastika, o reali rizika, reikalaujanti skubių tarptautinių veiksmų.

Apie šią grėsmę pranešta tarptautinio susitikimo metu Paryžiuje, kur ekspertai aptarė sparčiai progresuojančius dirbtinio gyvybės kūrimo tyrimus. Daugiau nei 30 mokslininkų, tarp jų – du Nobelio premijos laureatai, paragino stabdyti eksperimentus, kurie, jų teigimu, gali sukelti „ekstremalią ir potencialiai egzistencinę grėsmę“ gyvybei Žemėje.
Kas tie „veidrodiniai mikrobai“?
Gyvybę Žemėje sudarantys biologiniai junginiai – nukleotidai ir aminorūgštys – pasižymi vadinamuoju chirališkumu: jie egzistuoja tarsi kairės ir dešinės rankos atitikmenys. Natūralioje gyvybėje naudojami tik vienos krypties junginiai – pavyzdžiui, baltymai iš „kairiarankių“ aminorūgščių.
Tačiau mokslininkai eksperimentuoja kurdami šių molekulių „veidrodinius“ analogus. Tokie organizmai – jei būtų sukurti – galėtų veikti visiškai skirtingai nei bet kuris gyvas padaras Žemėje.
Ir tai kelia nerimą.
Invazinė rūšis, galinti pakeisti viską?
„Turėtume būti labai susirūpinę“, – įspėjo Stanfordo universiteto mikrobiologas Davidas Relmanas, kalbėdamas su Financial Times. – „Veidrodinis organizmas teoriškai galėtų tapti invazine rūšimi, kuri išstumia esamas gyvybės formas ir sukelia chaosą planetos ekosistemoms – įskaitant ir žmonių aplinką.“
Pasak ekspertų, tokio organizmo atsiradimas gali tapti planetiniu įvykiu – negrįžtamu ir galinčiu pakeisti gyvybės Žemėje eigą. O blogiausiu atveju – ją nutraukti.
Kol kas prognozuojama, kad veidrodinis gyvenimas realiai gali būti sukurtas ne anksčiau kaip po dešimtmečio, tačiau žala gali būti nevaldoma, jei jis išslys iš laboratorijų.
Ar tai tik bauginimas?
Ne visi mokslininkai sutinka su katastrofiškais scenarijais. Davidas Bikardas, Pastero instituto sintetinės biologijos vadovas, ramina, kad „veidrodiniai mikrobai galbūt jau kažkada egzistavo ir išnyko“, o pavojus gali būti perdėtas.
Vis dėlto net jis pripažįsta: „Yra daug nežinomųjų. Ir egzistuoja scenarijus, kuriame tai virsta katastrofišku įvykiu.“
Mokslas peržengia ribas – ar žmonija pasiruošusi?
Veidrodinių molekulių šalininkai viliasi, kad šie organizmai gali būti revoliucinis proveržis medicinoje – padėti gydyti lėtines, sunkiai įveikiamas ligas. Tačiau skeptikai primena: tokie mikroorganizmai gali būti sunkiai kontroliuojami, ypač jei patektų į natūralią aplinką.
Vienas aišku – mokslas jau seniai peržengė tradicines ribas, o klausimas nebe „ar tai įmanoma“, o „ar tai saugu“. Ir kol pasaulis svarsto, ar kurti veidrodinę gyvybę, kai kurie ekspertai jau įžvelgia joje – galimą pasaulio pabaigą.

Sveiki, aš esu Darius Jakelionis – žmogus, mėgstantis dalintis įvairiapusiu turiniu. Rašau naujienas, straipsnius ir aktualijas, o taip pat kuriu kiek lengvesnio pobūdžio turinį – maisto receptus bei horoskopus. Mano tikslas – pateikti skaitytojams tiek naudingos informacijos, tiek įkvėpimo ar net pramogos. Noriu, kad kiekvienas apsilankęs rastų ką nors įdomaus ir vertingo sau.
